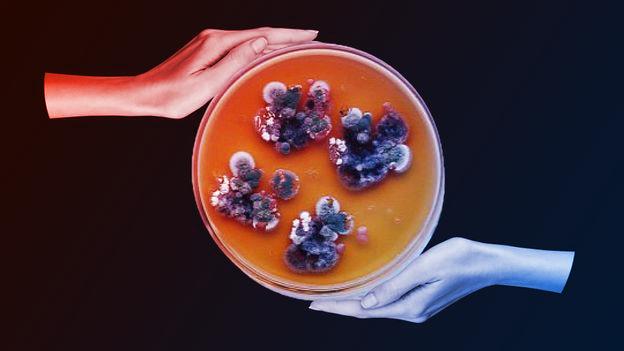
A sugárzást faló titokzatos fekete gomba

Az élet visszatér Csernobilba
Kezdetben, 1997 májusában Nelli Zhdanova kutató bement az atomerőmű radioaktív romjai közé, ahol meglepetésére a falakat, a mennyezetet és még a fémkábeleket védő csatornákat is sűrűn borította egy fekete penész. A kinti erdőkben a természet időközben visszafoglalta a területet, ám a radioaktív gócpontokban Zhdanova először találkozott azzal a jelenséggel, hogy a penészgomba fonalai épp a sugárzás forrását keresik. Miközben a sugárzás a legtöbb élőlényt elpusztítja, ezek a penészgombák – több különböző faj egyvelege – az atomreaktor belső tereibe is behatoltak, ahol a sugárszint a legmagasabb.
Hogyan fordulhat ez elő?
A helyzet drámaian alakult a balesetet követően: 1986. április 26-án az atomerőmű 4-es reaktorának hibás tesztje robbanáshoz és radioaktív anyagok, például a jód szétszóródásához vezetett. Az egészségi kockázat csökkentésére 30 kilométeres lezárt övezetet hoztak létre, ahol az emberek nem tartózkodhattak, de a fekete gomba lassan meghódította a területet. Zhdanova kutatásai felfedezték, hogy ezek a gombák radioaktív talajban nőnek, sőt igyekeznek elérni a sugárzás forrását.
A jelenségre külön nevet is adtak: radiotropizmus. Ez azt jelenti, hogy a gombafonalak – hasonlóan ahhoz, ahogy a növények a fény felé nőnek – éppen a sugárzás forrását keresik, holott az ionizáló sugárzás általában halálos.
Melanin: a természet sugárpáncélja
A gombák túlélési képességének kulcsa egy pigment: a melanin. Ez a fekete vagy vörösesbarna színű molekula felelős az emberek bőrszínéért is, de ugyanúgy a csernobili gombák sötét színéért. A kutatók észrevették, hogy a magas melanintartalmú szervezetek (például a helyi békák is) sötétebbek, a pigment pedig kiválóan védi a sejteket a káros sugárzástól.
A melanin azonban nem olyan, mint egy külső pajzs: a beérkező szabad gyököket és ionokat stabilizálja, így akadályozva meg a biológiai károsodást.
Mondhatni, sugárzással táplálkozó élőlények
Ezenfelül a melaninnal rendelkező gombákról 2007-ben egy újabb áttörés született: Ekaterina Dadachova kísérletei igazolták, hogy radioaktív környezetben a melanizált gombafajok 10%-kal gyorsabban nőnek, ráadásul a sugárzást az anyagcseréjük támogatására használják fel. Ez már nem pusztán radiotropizmus, hanem aktív „radioszintézis” lehet: a gombák képesek kihasználni a sugárzás energiáját, ahogyan a növények a napfényt használják a fotoszintézishez.
A pontos működési elv még rejtély, de a radioszintézis elmélete szerint a melanin átalakítja az ionizáló sugárzás rendkívül nagy energiáját a gombák számára felhasználható formára.
A sugárzástól védő űrgomba?
Nem minden melanizált gomba nő radiotrop módon, de a csernobili Cladosporium sphaerospermum a laboratóriumi kísérletek szerint is kifejezetten sugárzást kedvelő. 2018-ban ez a gombafaj az űrben, 26 napon át kozmikus sugárzásnak kitéve, 21%-kal gyorsabban nőtt, mint Földön tartott testvérei. Ezenfelül a gombaréteg a Nemzetközi Űrállomáson bizonyítottan elnyelte a káros sugárzás egy részét: már vékony penészréteg is hatékony pajzsként szolgált.
Igaz, nem biztos, hogy csak a melanin játszik védőszerepet: például a víz is remek sugárzáselnyelő, hiszen sok protonból áll. Ugyanakkor a felfedezés új ötleteket adott: az űrutazáshoz, hold- vagy marsbázisokhoz szükséges vastag víz- vagy műanyagburkolatok súlya problémás, hosszú távon ezek miatt a teljes űrbázisokat nem érdemes csak a Földről szállítani.
Az űrépítészet új iránya
A NASA, az Európai Űrügynökség és a SpaceX mind bázist terveznek a Holdra vagy a Marsra. Ehhez azonban sugárzásvédő anyag kell, amit nem célszerű a Földről felvinni. Erre kínálhat megoldást a helyben termeszthető bioépítészet: mikrogombák, gombából szőtt struktúrák. Ha a penészgomba-kutatások eredményei igazolódnak, akkor a jövőben ezek a sötét, önregeneráló gombafalak jelenthetnék a pajzsot a világűr gyilkos sugárzásával szemben.
Ezenfelül, ahogy a fekete penész Csernobilban meghódította a sugárveszélyes birodalmat, úgy teheti majd biztonságosabbá az emberiség első lépéseit idegen bolygókon is.











